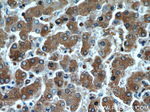
Alpha-1-Antitrypsin Antibody in Immunohistochemistry (Paraffin) (IHC (P))

Search
Proteintech
Alpha-1-Antitrypsin Monoclonal Antibody (1A9G6)
{{$productOrderCtrl.translations['antibody.pdp.commerceCard.promotion.promotions']}}
{{$productOrderCtrl.translations['antibody.pdp.commerceCard.promotion.viewpromo']}}
{{$productOrderCtrl.translations['antibody.pdp.commerceCard.promotion.promocode']}}: {{promo.promoCode}} {{promo.promoTitle}} {{promo.promoDescription}}. {{$productOrderCtrl.translations['antibody.pdp.commerceCard.promotion.learnmore']}}
产品信息
66135-1-IG
种属反应
宿主/亚型
分类
类型
克隆号
抗原
偶联物
形式
浓度
规格
纯化类型
保存液
内含物
保存条件
运输条件
产品详细信息
Immunogen sequence: QGDAAQKTD TSHHDQDHPT FNKITPNLAE FAFSLYRQLA HQSNSTNIFF SPVSIATAFA MLSLGTKADT HDEILEGLNF NLTEIPEAQI HEGFQELLRT LNQPDSQLQL TTGNGLFLSE GLKLVDKFLE DVKKLYHSEA FTVNFGDTEE AKKQINDYVE KGTQGKIVDL VKELDRDTVF ALVNYIFFKG KWERPFEVKD TEEEDFHVDQ ATTVKVPMMK RLGMFNIQHC KKLSSWVLLM KYLGNATAIF FLPDEGKLQH LENELTHDII TKFLENEDRR SASLHLPKLS ITGTYDLKSV LGQLGITKVF SNGADLSGVT EEAPLKLSKA VHKAVLTIDE KGTEAAGAMF LEAIPMSIPP EVKFNKPFVF LMIEQNTKSP LFMGKVVNPT QK (28-418 aa encoded by BC015642)
靶标信息
Alpha-1-AT is synthesized in the liver and it acts as an inhibitor of proteases such as trypsin, elastase, chymotrypsin, collagenase, leucocytic proteases, plasmin, and thrombin, which may be released during inflammatory reactions in the lung. In the absence of alpha-1-AT, these enzymes are not inhibited and they may digest pulmonary parenchyma. Alpha-1-AT deficiency is associated with chronic obstructive lung disease (emphysema) and less frequently with hepatic cirrhosis in infants and respiratory distress of the newborn. Increase in alpha-1-AT occurs as an acute phase response to tissue necrosis and inflammation. Serum level of alpha-1-AT is elevated in rheumatoid arthritis, bacterial infections, vasculitis, and carcinomatosis.
仅用于科研。不用于诊断过程。未经明确授权不得转售。
生物信息学
蛋白别名: a-1 AT; a1-antitrypsin; AAT; alpha 1 antitrypsin; alpha-1 antitrypsin; Alpha-1 protease inhibitor; Alpha-1 protease inhibitor 1; alpha-1 proteinase inhibitor; Alpha-1-antiproteinase; Alpha-1-antitrypsin; alpha-1-antitrypsin (alpha-1-AT); alpha-1-antitrypsin (protease inhibitor); Alpha-1-antitrypsin 1-1; alpha-1-antitrypsin 2; alpha-1-protease inhibitor; Alpha-1-proteinase inhibitor; anti-elastase; Digestive Zymogen; epididymis secretory sperm binding protein; MGC23330; MGC9222; protease inhibitor; protease inhibitor 1 (anti-elastase), alpha-1-antitrypsin; Protease Serine 1; proteolytic enzyme inhibitor; serine (or cysteine) proteinase inhibitor, clade A (alpha-1 antiproteinase, antitrypsin), member 1; serine (or cysteine) proteinase inhibitor, clade A, member 1; serine (or cysteine) proteinase inhibitor, clade A, member 1a; Serine Protease 1; Serine protease inhibitor 1-1; Serine protease inhibitor A1a; serine protease inhibitor alpha 1; Serpin A1; Serpin A1a; serpin peptidase inhibitor clade A (alpha-1 antiproteinase antitrypsin) member 1 isoform SERPINA1_1; serpin peptidase inhibitor clade A (alpha-1 antiproteinase antitrypsin) member 1 isoform SERPINA1_2; serpin peptidase inhibitor clade A (alpha-1antiproteinase, antitrypsin) member 1; serpin peptidase inhibitor clade A member 1; serpin peptidase inhibitor, clade A (alpha-1 antiproteinase, antitrypsin), member 1; TRP1; TRY1; unnamed protein product
基因别名: A1A; A1AT; AAT; Aat-2; Aat2; alpha1AT; Dom1; nNIF; PI; PI1; PRO0684; PRO2209; PRO2275; SERPINA1; Serpina1a; Spi1; Spi1-1; Spi1-3
UniProt ID: (Pig) P50447, (Human) P01009, (Rat) P17475, (Mouse) P07758
Entrez Gene ID: (Pig) 397688, (Human) 5265, (Rat) 24648, (Mouse) 20700